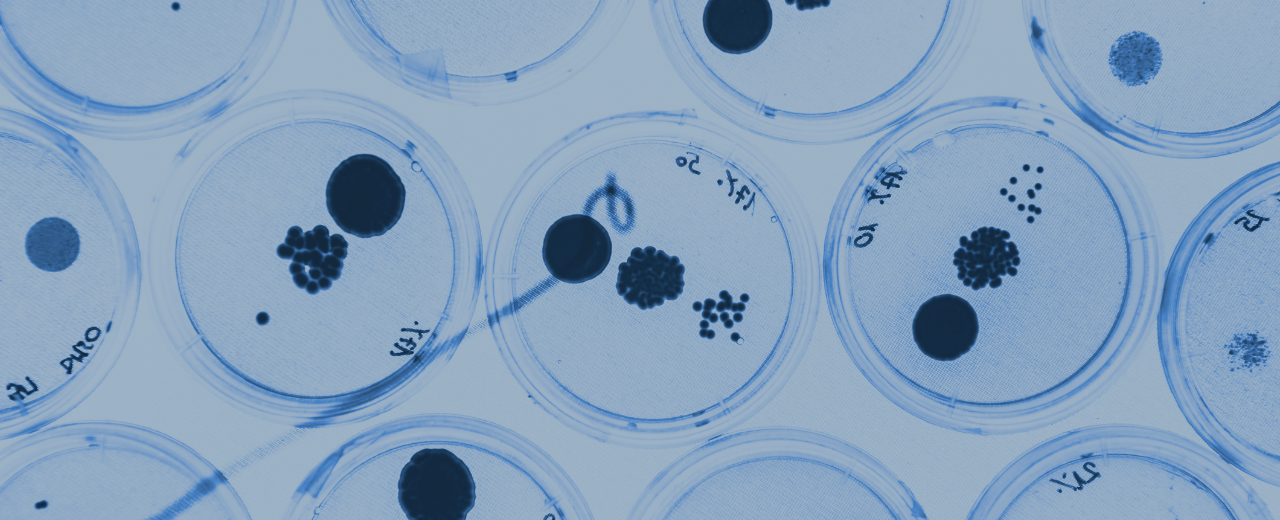
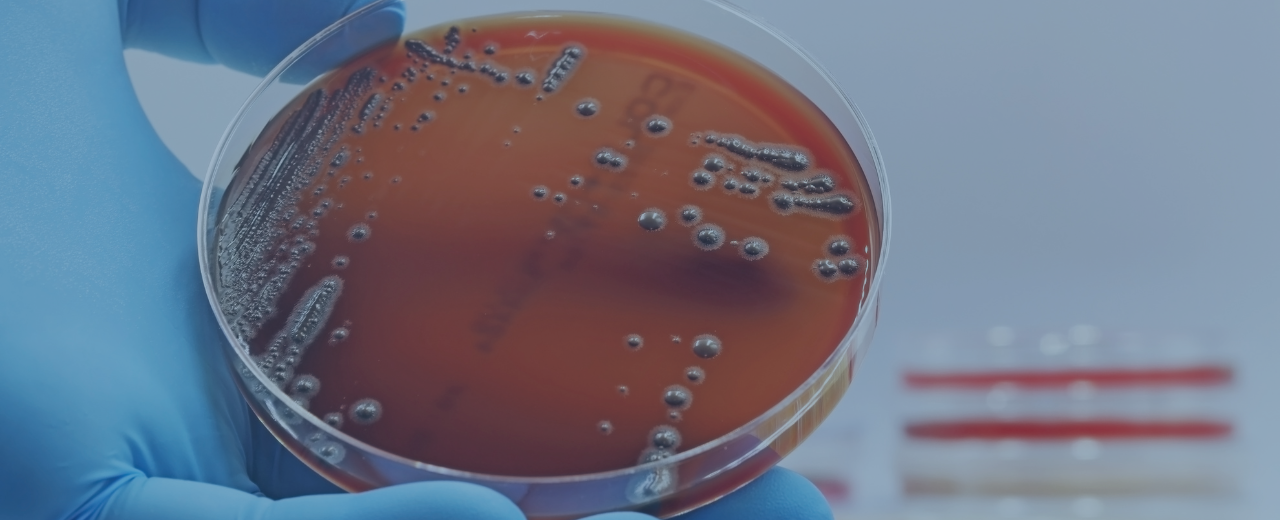
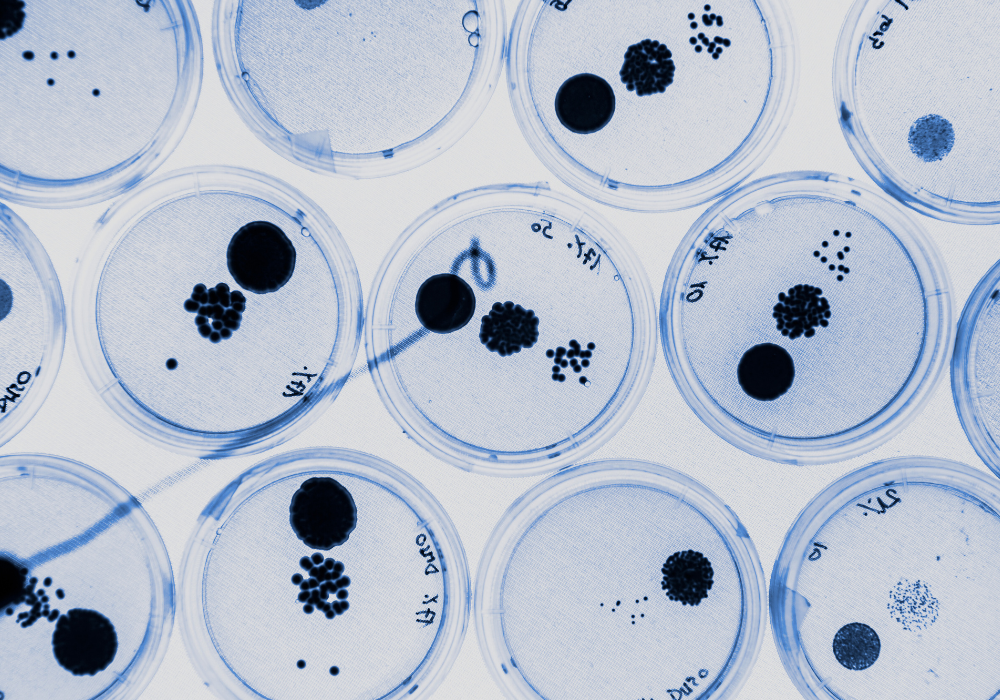

Micro 101 & EMP 101
UNLOCK THE BASICS OF EMP IN FOOD MANUFACTURING
Are you ready to demystify microbiology and environmental monitoring?
This free mini-course is designed to give you the foundational knowledge you need, without the fluff. Whether you're in packaging, distribution, or any part of the food manufacturing industry where microbes aren't top of mind, this course will help you understand the essentials and confidently explain why you do—or don't—need to worry about microbiological controls.
Understand the Basics Without the Overwhelm
We know that environmental monitoring can be a daunting subject, especially if it's not part of your daily routine.
This course breaks down complex concepts into simple, digestible information, ensuring you get the facts without feeling overwhelmed.

Justify Your Practices with Confidence
Whether you're working in a facility with minimal risk or a high-stakes environment, it's crucial to be able to explain why your practices are sufficient.
This course will arm you with the language and understanding to justify your programs and fend off unnecessary scrutiny.
Prepare for What's Next
This mini-course is just the beginning. By the end, you'll have a solid grasp of the basics, setting the stage for our upcoming webinar on Risk and Environmental Monitoring.
If you're ready to strengthen your ability to defend simple programs without becoming a microbiology expert, this is where to start.
What You'll Learn
- Microbiology 101: A straightforward introduction to the science of microbes and why they matter.
- Environmental Monitoring Fundamentals: Learn how to determine whether you need an EMP and what it might look like for your facility.
- Risk Justification: Gain the tools to explain and defend your current practices using the concepts and vocabulary of microbiology and risk management.
Check out the first four lessons below,
where we cover Micro 101 ⬇️
Course Contents
What Are Microbes?
A quick look at the cast of characters before we start describing some of their characteristics.
Microbes Aren't All Bad
People quickly reach for the atomic bomb. Let's not be alarmist and avoid any crazy reactions.
Factors Affecting Microbial Growth
If you don't need an EMP, these are the factors we will use to justify that you don't need one.
If you do need an EMP, we will use these same factors to categorize the risk and decide what your programs needs to look for.
Microbes Grow Exponentially
Understanding linear vs exponential growth is very important when it comes to interpreting your monitoring results, and to knowing which actions are appropriate and which ones aren't.
What is an EMP?
The role of an EMP is to verify and validate micro controls. Any confusion about that role leaves you in the left field - things stop making sense, and everything gets really complicated. We don't want that to happen.
Parts of an EMP
If you're going to drive a car, you need to understand the basic parts of the car and what their roles are: the steering wheel, the brakes, the gas pedal...
The same goes for any food safety program.
What's an Indicator Organism?
We can't look at every microbe. How do we choose which ones to look at?
Selecting Pathogens for an EMP
We will focus on Salmonella and Listeria during the webinar. Here, we explain why. For entry-level micro, these two cover all the bases.
Want Access to EMP 101?
This course is completely free—no credit card required!
To get access to the full mini-course, including Micro 101 & EMP 101, simply add it to your cart by clicking below and complete the checkout process to register. Instructions on how to access the course will be emailed to you once you're registered.
Couldn't load pickup availability

-
💭 What's Next?
After completing this mini-course, be sure to watch our webinar replay on Integrating Risk in Your Environmental Monitoring Program, where we dive deeper into how to defend your programs and manage risks effectively.
If you're ready to take your knowledge to the next level, watch the webinar at the link below.
- Choosing a selection results in a full page refresh.
- Opens in a new window.